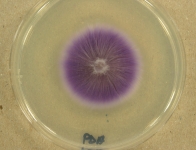

<< back to search
IMAGES:
Search Details
add to cart
| UAMH Number: | 8232 |
|---|---|
| Species Name: | Laccaria bicolor |
| Type: | |
| Synonyms: | Laccaria bicolor var. pseudobicolor / Laccaria laccata var. bicolor / Laccaria laccata var. pseudobicolor / Laccaria proxima var. bicolor |
| Taxonomy: | FUNGI Basidiomycota, Agaricomycetes, Agaricales, Hydnangiaceae |
| Strain History: | Khasa, P.D. (CRBF 92.9) -> UAMH |
| Substrate: | Pinus banksiana roots | Location: | CANADA Ontario, Burt Lake (GEO: 48.072,-80.372) |
| Isolator: | |
| Isolation Date: | 1992 |
| Date Received: | 1995-09-11 |
| Characters: | CULTURE CONDITIONS clamps - // MYCORRHIZAE most persistent inoculant strain in outplanted seedlings - Gagne et al 2006 // MYCORRHIZAE persistence of introduced ectomycorrhizal fungi in outplanted seedllings - Gagne A, Jany J-L, Bousquet J, Khasa PD, Can J For Res 36:1684-1694, 2006 // MYCORRHIZAE responses of ectomycorrhizal Populus tremuloides and Betula papyrifera seedlings to salinity - Yi H, Calvo Polanco M, MacKinnon MD, Zwiazek JJ, Environmental and Experimental Botany 62:357-363, 2008 // MYCORRHIZAE responses of ectomycorrhizal Ulmus americana seedlings to salinity and soil compaction - Calvo Polanco M, Jones MD, Zwiazek JJ, Acta Physiol Plant 31:515-522, 2009 // MYCORRHIZAE responses of ectomycorrhizal Ulmus americana seedlings to salinity and soil compaction - Calvo Polanco M. Zwiazek JJ, Voicu MC, Plant Soil 308:189-200, 2008 // MYCORRHIZAE role of ectomycorrhizal fungi in mineral weathering - Adeleke RA, Cloete TE, Bertrand A, Khasa DP, Mycorrhiza Epub Feb 2012 // MYCORRHIZAE salt tolerant - Bois G, Bertrand A, Piche Y, Fung M, Khasa DP, Mycorrhiza 16:99-109, 2006 // MYCORRHIZAE salt tolerant - Bois G, Bigras FJ, Bertrand A, Piche Y, Fung MY, Khasa DP, Tree Physiology 26:1185-1196, 2006 // MYCORRHIZAE salt tolerant - candidate for inoculation of tree seedlings in salt-affected soil // MYCORRHIZAE salt tolerant - Kernaghan, Hambling, Fung & Khasa, Restoration Ecology 10:43-51, 2002 // MYCORRHIZAE simple sequence repeat (SSR) markers for environmental monitoring of Laccaria bicolor - Jany J-L, Bousquet J, Gagne A, Khasa DP, Mycol Res 110:51-59, 2006 (Click for publications citing UAMH 8232) |
| Compounds: | |
| Cross Reference: | |
| Collections: | Living Strains; Dried Herbarium Material |
| Pathogenic Potential: | Human: no | Animal: no | Plant: no |
| Biosafety Risk Group: | RG1 (check the PHAC ePATHogen Risk Group Database for updates) |
| Regulatory Requirements: | No restrictions for Canadian requesters. International requesters must provide all legally required importation documentation prior to shipment. Plant pathogenicity status may be verified by using the USDA Agricultural Research Service (ARS) Fungal Database |
| MycoBank ID: | 332790 |
IMAGES: